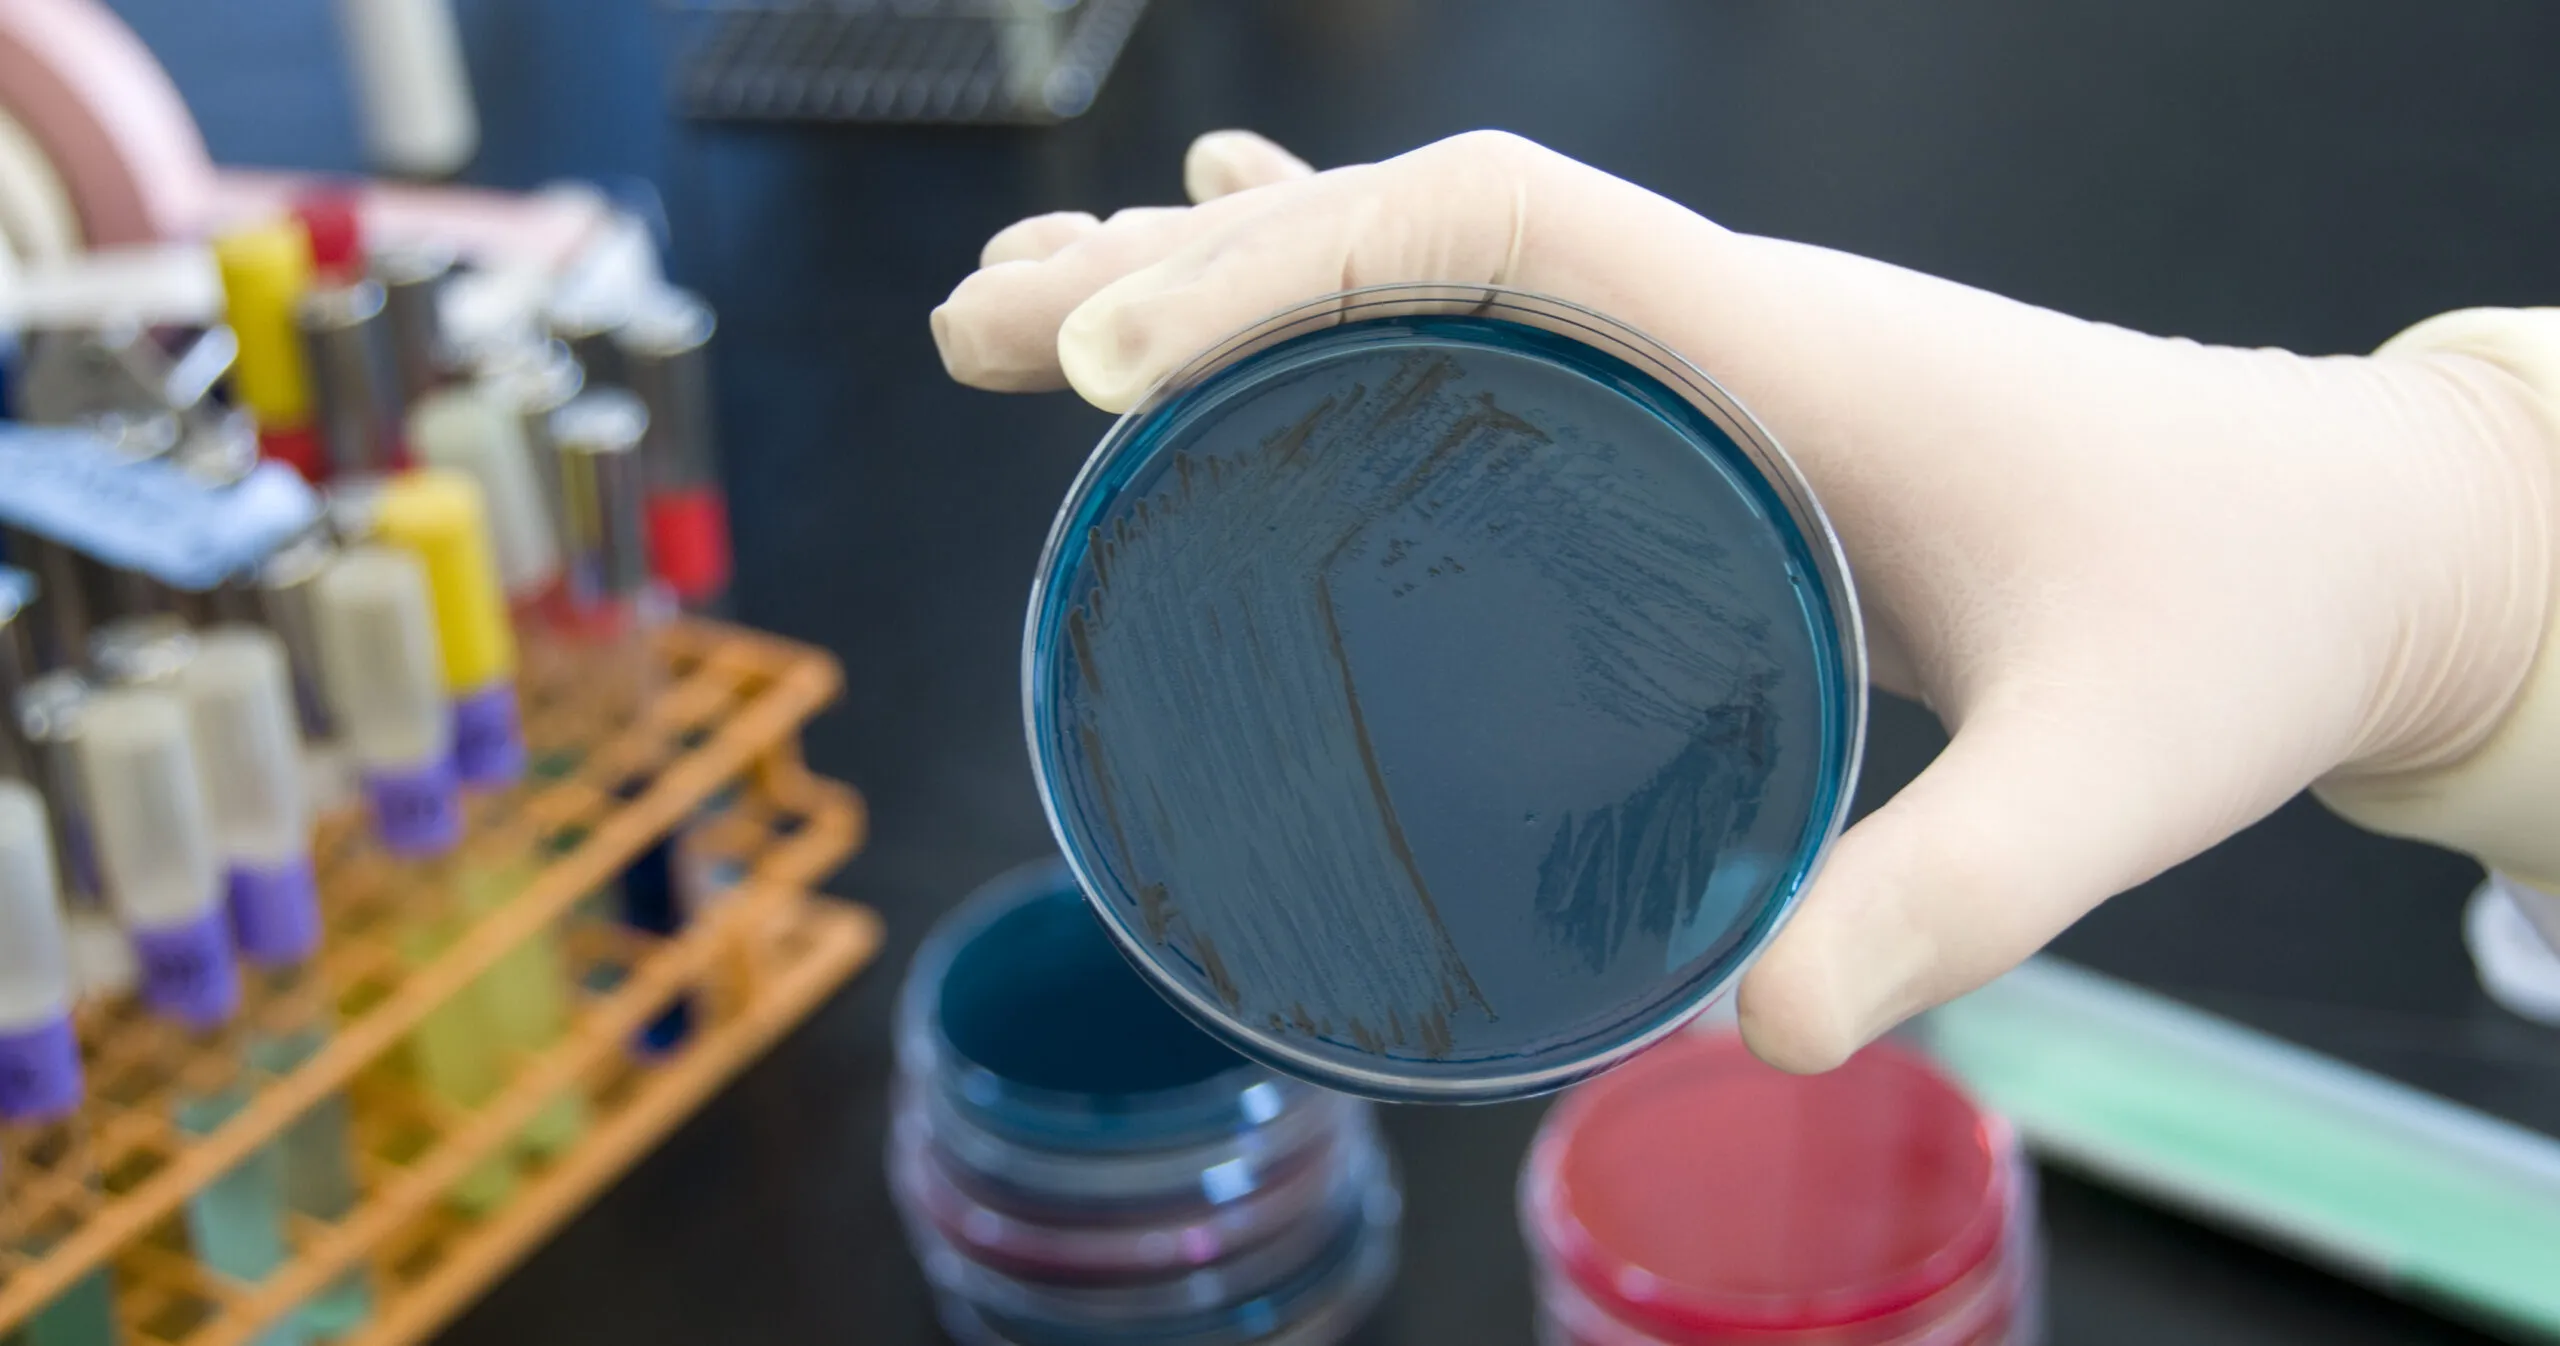
Зображення до новини

На початку березня п’ятьох вінничан госпіталізували до лікарні після відвідування супермаркету ТОВ “ЕКО” (“Екомаркет”), у всіх них згодом виявили інфекційне захворювання.
Як повідомляє Держпродспоживслужба Вінниччини, усім хворим встановлений уточнений діагноз – “Сальмонельоз середнього ступеня важкості”. Вони продовжують стаціонарне лікування.
Нагадаємо, першого березня в інфекційне відділення вінницької міської клінічної лікарні №1 госпіталізували п’ятьох дорослих вінничан. Усі потрапили туди з діагнозом “гострий гастроентероколіт” після того, як відвідали супермаркет ТОВ “ЕКО”, що на проспекті Коцюбинського, 70.
“Із 8 відібраних проб готових страв на відповідність ДСанПіН 4.4.5.078-2001 у 50 % проб виявлені відхилення. Із 5 проб продукції не відповідає ДСТУ 5028-2008 1 зразок – яйця сирі, у яких виявлено Salmonella Enteritidis. Із 17 зразків змивів на санітарно-показову мікрофлору та патогенні ентеробактерії у 5 змивах виявлено бактерії групи кишкової палички. Проба води питної водопровідної відповідає ДСанПіНу 2.2.4-171-10″, – йдеться у повідомленні.
За результатами лабораторного дослідження, у персоналу ТОВ “ЕКО” на кишкову групу інфекцій, патогенних ентеробактерій, в тому числі сальмонели, не виявлено.
В супермаркеті проведено комплекс протиепідемічних заходів та заключна дезінфекція. Директора закладу ТОВ “ЕКО” притягнуто до адміністративної відповідальності, діяльність закладу тимчасово призупинена до усунення виявлених недоліків.

Дякуємо!
Тепер редактори знають.